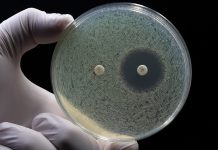
£30m funded PACE initiative announced to combat antimicrobial resistance globally antimicrobial resistance

Mpox Explained: Everything You Need to Know About This Viral Outbreak
Curious about Mpox? Wondering how this viral outbreak could impact you or your community? From its origins to prevention strategies and potential global implications,...
The importance of robust cleaning in patient care
Understanding the correct cleaning processes and protocols for different environments is integral to mitigating the threat of infectious diseases and maintaining high levels of...
The Role of Environmental Hygiene in Preventing Infections
Navigate the intricate web of infection prevention through the lens of environmental hygiene, revealing unseen layers vital for safeguarding public health.
Maintaining environmental hygiene is...
New tetanus test identifies global immunity gaps
Researchers from the University of Birmingham are developing a non-invasive saliva test that could identify children across the Global South missing immunity to tetanus...
NIH-sponsored trial of nasal COVID-19 vaccine opens
A Phase 1 trial testing the safety of an experimental nasal vaccine that may provide enhanced breadth of protection against emerging variants of SARS-CoV-2,...
Could genes be the answer to personalised sepsis treatment?
Sepsis is a life-threatening infection and affects people in a multitude of ways depending on genetic makeup. A team of researchers has uncovered how...
Understanding the Scope of Healthcare-Associated Infections in 2024
Learn about the escalating challenge of healthcare-associated infections in 2024 and discover the innovative strategies being employed to combat this issue.
New biomarkers to enable personalised flu vaccine schedule
Researchers have developed a method that could enable a personalised flu vaccine schedule for long-lasting immunity.
Influenza affects up to five million people worldwide...
New molecule suppresses bacterial antibiotic resistance
University of Oxford researchers have developed a new small molecule that can suppress the evolution of antibiotic resistance in bacteria.
Antibiotic resistance is a...
Pandemic preparedness in 2024: Lessons learned and future directions
The COVID-19 pandemic has underscored the critical importance of pandemic preparedness and shaping more resilient healthcare systems.
Measles vaccine less likely to work for C-section children
Researchers from the University of Cambridge have emphasised that children born by caesarean section must receive two doses of the measles vaccine for robust...
52% of England’s care home residents get spring COVID-19 vaccine
NHS England confirms that over half of England’s care home residents have received their spring COVID-19 vaccine.
In April 2024, the NHS booking system for...
New model reveals how malaria transmission is affected by climate change
The University of Leeds has pioneered a new model for monitoring how climate change is affecting malaria transmission in Africa.
Previous methods to predict how...
Duke University creates long-lasting flu vaccine
Duke University researchers have unveiled a promising breakthrough in the ongoing battle against influenza viruses.
Their pioneering research has developed a universal, long-lasting flu vaccine...
The implications of antibiotic use in farming
Jane Tredgett, Campaigns Manager at Alliance to Save Our Antibiotics, discusses the effects of routine antibiotic use in intensive livestock farming and why it...
NHS launches MMR vaccine catch-up campaign
The NHS in England has embarked on a campaign to ensure that more than 900,000 adults aged 19 to 25 receive their missed MMR...
Broadening research and awareness of AMR
Jonathan Pearce, CEO of Antibiotic Research UK discusses the charity’s efforts in creating new therapeutics to tackle antibiotic-resistant infections, and the actions needed to...
Disease X: Researchers analyse virus ancestry to predict next global pandemic
In the fight against infectious diseases, scientists are digging into the family trees of viruses to predict which one might cause the next big...
mRNA vaccines: are they the way forward?
mRNA vaccine technology is broadening the scope of effective vaccine-based solutions that can mitigate the spread of harmful pathogens in infectious and non-infectious diseases.
For...
£30m funded PACE initiative announced to combat antimicrobial resistance globally
In a significant collaborative effort to combat antimicrobial resistance, Innovate UK, LifeArc, and Medicines Discovery Catapult (MDC) have combined to launch the £30m funded...